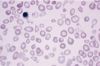

RBC disorder pt 1 Flashcards
how do you classify anemias based on their mean corpuscular values (MCV)?
- Microcytic anemias: MCV less than 80
- Macrocytic anemias: MCV more than 100
- Normocytic anemias: MCV between 80 to 100
What are the causes of Microcytic anemias?
- Iron deficiency anemia
- Anemia of Chronic Disease
- Thalassemias (β and α)
- Sideroblastic Anemias
iron deficiency causing microcytic anemia occurs mostly on who in the population?
young children and women
is iron actively secreted from the body?
no
how do we eliminate iron from the body?
- loss of epithelial cells from GIT,
- epidermal cell loss from skin,
- women in reproductive age
how is iron balance achieved?
iron out of body must be equally intaked
in what organ is iron absorbed?
what part of the organ?
what 2 pathways are used?
intestine
duodenum
Pathways:
1) uptake of heme iron
2) dietary non-heme
uptake of heme iron pathway
heme iron is derived from what molecule?
what portion does the uptake of heme iron in intestine make?
what cells uptake the heme protein in the duodenum? what happens inside the cell?
Hb
2/3 of iron is uptaked though heme derived proteins
mucosal cells, heme oxygenase cleaves the porphyrin ring (heme is available for absorption htorugh non-heme pathway)
dietary non-heme pathway
dietary non-heme is mostly present as what type of molecules?
what is an important factor in order to uptake this inorganic iron?
ferric hydroxide or bound to phytates, oxalates, sugars, citrate, lactate
low gastric pH
Molecular mechanism of iron absorption
what enzyme do enterocytes use to import ferrous iron?
where do enterocytes express this enzyme?
can the enzyme be used to import ferric iron?
DMT1
expressed in apical surface
no
Molecular mechanism of absorption of iron
non-heme is in ferric or ferrous state?
can this be transported by DMT1?
what has to be used? what does it do?
ferric
no
needs CYBRD1 to reduce ferric non-heme to ferrous so that DMT1 later can absorb it
Molecular mechanisms of iron absorption
what happens to iron once it is absorbed by enterocytes?
what do you call iron in the plasma?
iron from enterocyte is transferred to plasma using FPN1 (ferroportin 1) to export it (outside)
transferrin
Molecular mechanisms of iron absorption
where is transferrin made?
how many of the available transferrin binding sites are occupied by iron? why that amount?
liver
only one-third, in case there is excess iron
Molecular mechanisms of iron absorption
whan happens to iron once it is in the plasma? (where does it go?)
once it is transferred to the other cell, what organelle uses up most of this iron 80-90%?
the other 10-20% of iron, where does it go?
iron is delivered to erythroid precursors (nomoblasts) by using transferrin receptors
mitochondria
rest of iron is stored as ferritin
what are sideroblasts?
what stain can be used to view granules in sideroblasts?
normoblasts with granules
prussian blue
how do sideroblast look in sideroblastic anemia?
ring-like
Molecular mechanisms of iron absorption
what cell type can recycle iron?
macrophages
Molecular mechanisms of iron absorption
how do alveolar macrophages recycle iron?
what is the exception after alveolar macrophages recycle iron?
- they phagocytose erythrocytes & convert the iron to storage form
- the iron cannot be returned to circulation
what other type of macrophage can recycle iron?
what are the forms used to store iron in macrophages?
reticulo-endothelial macrophages
- ferritin
- hemosiderin
what is ferritin?
in what cells is ferritin seen?
in what fluid compartment can ferritin be seen in small amounts?
protein that stores iron and releases it in controlled manner
seen in all cells
plasma
what is the difference between ferritin and hemosiderin?
hemosiderin has:
- higher amount of iron than protein
- is less soluble in aqueous solution
- is more stable and less available
Iron deficiency anemia
when is iron deficiency anemia seen?
how is it corrected?
when are symptoms seen?
- when iron balance tilts to negative
- mobilizing the iron stores
- when the tissue stores are depleted
Iron deficiency anemia
the deficiency is seen due to what reasons?
- dietary lack of iron
- impaired absorption
- there is increased use of it
(like in growth or menstruation, pregnancy)
- chronic blood loss
(peptic ulcer disease, hemmorrhoids, carcinoma of stomach/colon, aspirin, ulcerative colitis, esophageal varices)
when can you have unexplained iron deficiency anemia?
H. pylori infection